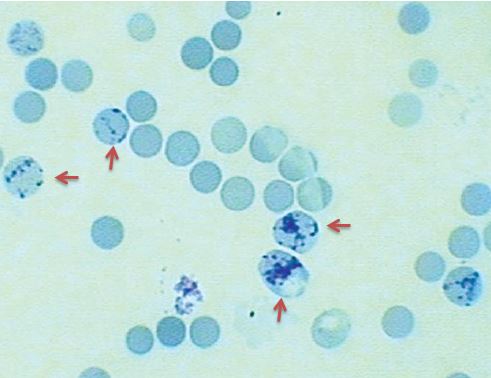

Description
DESCRIPTION
Application
Utilizes New Methylene Blue for the identification of reticulocytes in blood films. Reticulocyte Stain has been used in the detection of reticulocytes.
Principle
Blood and reticulocyte staining solution (New Methylene Blue) are mixed and incubated briefly at room temperature. Wedge or spun smears are made on microscope slides, air dried and evaluated under oil immersion on a light microscope. A red blood cell scoring positive would be observed containing two or more blue-stained granules.
PROPERTIES
form
solution
Pack Size
120 mL
shelf life
Expiry date on the label.
IVD
for in vitro diagnostic use
application(s)
hematology
histology
storage temp.
room temp

Reviews
There are no reviews yet.